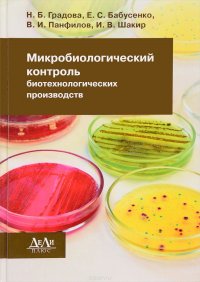

18+
На сайте представлено только описание и выходные данные книги «Микробиологический контроль биотехнологических производств Н. Б. Градова, В. И. Панфилов, Е. С. Бабусенко, И. В. Шакир». Сайт не является распространителем книги. Сайт не предоставляет возможности купить, читать онлайн или скачать бесплатно книгу «Микробиологический контроль биотехнологических производств Н. Б. Градова, В. И. Панфилов, Е. С. Бабусенко, И. В. Шакир». Сайт предназначен для лиц старше 18 лет. Если вам не исполнилось 18 лет - незамедлительно покиньте сайт. Оставаясь на сайте вы подтверждаете, что вам исполнилось 18 лет.
Незаконное потребление наркотических средств, психотропных веществ, их аналогов причиняет вред здоровью, их незаконный оборот запрещен и влечет установленную законодательством ответственность
В настоящем учебном пособии рассмотрены основы микробиологического контроля биотехнологических производств, включающих стадию культивирования микроорганизмов. Анализируется технологическая схема таких производств, возможные источники контаминации процессов, их генерирование и движение. Рассматривается структура микробиологического контроля и его значение для управления биотехнологическими процессами. В рамках пособия подробно описаны наиболее широко используемые методы, применяемые при микробиологическом контроле биотехнологических производств, которые могут быть реализованы в большинстве микробиологических лабораториях. Пособие является составной частью учебно-методического обеспечения подготовки бакалавров по программе высшего профессионального образования, обучающихся по направлению 19.03.01. "Биотехнология". Пособие будет полезно преподавателям, читающим курсы "Микробиология" и "Биотехнология" в учебных заведениях, а также научным работникам и... Это и многое другое вы найдете в книге Микробиологический контроль биотехнологических производств (Н. Б. Градова, Е. С. Бабусенко, В. И. Панфилов, И. В. Шакир)
| Полное название книги | Н. Б. Градова, В. И. Панфилов, Е. С. Бабусенко, И. В. Шакир Микробиологический контроль биотехнологических производств |
| Тип | Книга |
| Авторы | Н. Б. Градова, В. И. Панфилов, Е. С. Бабусенко, И. В. Шакир |
| Категории | Для техникумов и вузов, Образование и наука, Книги |
| ISBN | 9785905170881 |
| Возрастное ограничение | 18 |
| Издательство | ДеЛи плюс |
| Год | 2016 |
| Название транслитом | mikrobiologicheskiy-kontrol-biotehnologicheskih-proizvodstv-n-b-gradova-e-s-babusenko-v-i-panfilov-i-v-shakir |
| Просмотров | 10 |
| Рейтинг izbe.ru | 0,0 |

Мари Мур

Брук Лин

Конкордия Антарова

Дэниел Киз

Абрахам Вергезе

Аида Синицына

Вадим Зеланд

Сергей Лукьяненко

Роберт Грин

Виктор Дашкевич

Роман Прокофьев

Пауло Коэльо